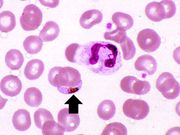
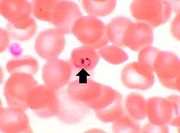
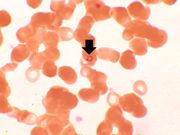

File list
This special page shows all uploaded files.
| Date | Name | Thumbnail | Size | Description | Versions |
|---|---|---|---|---|---|
| 04:58, 21 August 2013 | IPLab11Leishmaniasis5.jpg (file) |  |
38 KB | This is a high-power photomicrograph of an inflammatory cell containing cytoplasmic organisms (arrows). | 1 |
| 04:58, 21 August 2013 | IPLab11Leishmaniasis4.jpg (file) |  |
70 KB | This high-power photomicrograph of the biopsy specimen shows more clearly the heavily infiltrate of inflammatory cells. Note the small blue structures inside the inflammatory cells (arrows). | 1 |
| 04:58, 21 August 2013 | IPLab11Leishmaniasis3.jpg (file) |  |
58 KB | This is a higher-power photomicrograph of this biopsy. The ulcerated surface is seen on the top of the section. Again, note that the specimen is heavily infiltrated with inflammatory cells. | 1 |
| 04:58, 21 August 2013 | IPLab11Leishmaniasis2.jpg (file) |  |
13 KB | This is a low-power photomicrograph of the biopsy taken from this skin lesion. The ulcerated surface is at the top. Note that the specimen is heavily infiltrated with inflammatory cells. | 1 |
| 04:57, 21 August 2013 | IPLab11Leishmaniasis1.jpg (file) |  |
34 KB | In this photograph of the skin lesion seen in this patient, note the raised edges (arrows) and the ulcerated center. | 1 |
| 04:56, 21 August 2013 | IPLab11Malaria7.jpg (file) |  |
24 KB | In this peripheral smear from a different patient who was infected with P. vivax, the cytoplasm of the infected RBC has a stippled appearance (Schüffner's dots) (arrow). The RBC is also slightly enlarged. | 1 |
| 04:55, 21 August 2013 | IPLab11Malaria6.jpg (file) |  |
47 KB | This high photomicrograph was taken from another patient who died of malignant cerebral malaria caused by P. falciparum. In this photomicrograph, a small artery (arrow) can be seen that is full of parasitized RBCs. These RBCs tend to clog small blood v... | 1 |
| 04:55, 21 August 2013 | IPLab11Malaria5.jpg (file) | |
37 KB | There is another example of a P. falciparum gametocyte (arrow) in this thin smear. There is a neutrophil in this field as well. | 1 |
| 04:55, 21 August 2013 | IPLab11Malaria4.jpg (file) |  |
30 KB | In this high power photomicrograph of a thin smear of blood from this patient there is one P. falciparum gametocyte (arrow). These gametocytes have a characteristic "banana" shape. | 1 |
| 04:55, 21 August 2013 | IPLab11Malaria3.jpg (file) | |
22 KB | This is yet another high power photomicrograph of a thin smear of blood from this patient. There is one RBC that contains two ring stage trophozoites (arrow). This is characteristic of, but not diagnostic for, P. falciparum. | 1 |
| 04:54, 21 August 2013 | IPLab11Malaria2.jpg (file) |  |
36 KB | This is another high power photomicrograph of a thin smear of blood from this patient. There is a single eosinophil in this smear along with several RBCs containing ring stage trophozoites (arrows). | 1 |
| 04:54, 21 August 2013 | IPLab11Malaria1.jpg (file) | |
24 KB | This is a high power photomicrograph of a thin smear of blood from this patient. Note that one of the RBCs has a ring stage trophozoite (arrow). | 1 |
| 04:20, 21 August 2013 | IPLab10Mucor8.jpg (file) |  |
50 KB | This is another high-power photomicrograph of the thrombus stained to outline the Mucor organisms (arrows). | 1 |
| 04:20, 21 August 2013 | IPLab10Mucor7.jpg (file) |  |
51 KB | This is an even higher-power photomicrograph of the thrombus stained to outline the Mucor organisms (arrows). | 1 |
| 04:20, 21 August 2013 | IPLab10Mucor6.jpg (file) |  |
76 KB | This medium-power photomicrograph shows the thrombus stained to outline the Mucor organisms (arrows). Note again the ribbon-like morphology and the wide-angle branching. | 1 |
| 04:20, 21 August 2013 | IPLab10Mucor5.jpg (file) |  |
61 KB | This is another high-power photomicrograph of the wall of the artery and the thrombus. Within the thrombus there are multiple variably-shaped clear areas that represent longitudinal sections and cross sections of the Mucor organisms (arrows). | 1 |
| 04:19, 21 August 2013 | IPLab10Mucor4.jpg (file) |  |
40 KB | This is a higher-power photomicrograph of just the wall of the carotid artery. Note the ribbon-like clear structure with roughly parallel walls (non-septate hyphae) and right-angle branching (arrow). This is the Mucor organism. | 1 |
| 04:19, 21 August 2013 | IPLab10Mucor3.jpg (file) |  |
70 KB | This is an even higher-power photomicrograph of the wall of the carotid artery (1) and the thrombus (2). Within the wall of the artery and in the thrombus there are multiple variably shaped clear areas (3). At this magnification and with this stain, it... | 1 |
| 04:19, 21 August 2013 | IPLab10Mucor2.jpg (file) |  |
70 KB | This is a higher-power photomicrograph of the wall of the carotid artery (1) and the thrombus (2). | 1 |
| 04:19, 21 August 2013 | IPLab10Mucor1.jpg (file) |  |
38 KB | This is a low-power photomicrograph of a section of carotid artery containing a mural thrombus. | 1 |
| 04:17, 21 August 2013 | IPLab10Blasto10.jpg (file) |  |
39 KB | This is a very high-power photomicrograph showing Blastomyces organisms stained with PAS. Note the budding organism (arrow) and the underlying pyogranulomatous inflammatory reaction in the background. | 1 |
| 04:16, 21 August 2013 | IPLab10Blasto9.jpg (file) |  |
46 KB | This high-power photomicrograph shows Blastomyces organisms stained with PAS. Note the budding organism (arrow). Blastomyces has a characteristic presentation of budding which aids in diagnosis of the fungus. | 1 |
| 04:16, 21 August 2013 | IPLab10Blasto8.jpg (file) |  |
64 KB | This is a high-power photomicrograph showing an alveolus filled with Blastomyces organisms. This section is stained with Periodic Acid-Schiff (PAS) to stain the Blastomyces organisms. | 1 |
| 04:16, 21 August 2013 | IPLab10Blasto7.jpg (file) |  |
90 KB | This high-power photomicrograph shows an alveolus filled with numerous round bodies up to 25 mm in diameter. Some of these double-contour bodies (1) have a dense center and a clear halo. These are the Blastomyces organisms. The typical B. dermatitides ... | 1 |
| 04:16, 21 August 2013 | IPLab10Blasto6.jpg (file) |  |
103 KB | This high-power photomicrograph shows what appear to be inflammatory cells filling the alveoli. At this magnification, numerous round bodies (arrows) that look like inflammatory cell nuclei can be seen. However, on closer examination, some of these rou... | 1 |
| 04:16, 21 August 2013 | IPLab10Blasto5.jpg (file) |  |
79 KB | This is a higher-power photomicrograph of lung section with pleura. The pleura (arrows) is thickened and contains inflammatory cells and fibrin. The alveoli are filled with inflammatory cells. Some of the alveolar septa are congested with red blood cells. | 1 |
| 04:15, 21 August 2013 | IPLab10Blasto4.jpg (file) |  |
56 KB | This is a high-power photomicrograph of lung section with pleura. The pleura (1) is thickened and contains inflammatory cells and fibrin. The areas of consolidation (2) are dense and filled with inflammatory cells. | 1 |
| 04:15, 21 August 2013 | IPLab10Blasto3.jpg (file) |  |
26 KB | This is a low-power photomicrograph of lung showing many areas of consolidation (arrows). | 1 |
| 04:15, 21 August 2013 | IPLab10Blasto2.jpg (file) |  |
58 KB | This higher-power view of the lung shows more clearly the areas of necrosis (1) and consolidation (2). Satellite lesions are also present (3). | 1 |
| 04:15, 21 August 2013 | IPLab10Blasto1.jpg (file) |  |
56 KB | This gross photograph of the lungs shows areas of necrosis and consolidation. | 1 |
| 04:13, 21 August 2013 | IPLab10Crypto12.jpg (file) |  |
43 KB | This is a touch prep of fresh lung tissue that was allowed to air dry and then stained to show the mucopolysaccharide capsule around the cryptococcal organisms (arrows). | 1 |
| 04:12, 21 August 2013 | IPLab10Crypto11.jpg (file) |  |
61 KB | This is a higher-power photomicrograph of lung section stained with Alcian blue. The mucopolysaccharide capsule shrinks during processing with this stain, thereby producing a shrunken central appearance with the formation of spikes around each organism. | 1 |
| 04:12, 21 August 2013 | IPLab10Crypto10.jpg (file) |  |
84 KB | This is a low-power photomicrograph of lung section stained with Alcian blue, which stains the acidic glycosaminoglycans making up the coat of the cryptococcal organism. | 1 |
| 04:12, 21 August 2013 | IPLab10Crypto9.jpg (file) |  |
39 KB | This higher-power photomicrograph of a cryptococcal organism shows more clearly the nucleus surrounded by the large extracellular capsule (arrows). | 1 |
| 04:12, 21 August 2013 | IPLab10Crypto8.jpg (file) |  |
55 KB | Cryptococcal organisms can also be seen in this high-power photomicrograph of the cryptococcal lesion. Some of the organisms have a well-defined halo (arrows) due to the mucopolysaccharide coat which surrounds them. | 1 |
| 04:11, 21 August 2013 | IPLab10Crypto7.jpg (file) |  |
75 KB | This is another high-power photomicrograph of the cryptococcal lesion. In this section, numerous cryptococcal organisms (5-10 mm in diameter) can be seen (arrows). Note that there is very little inflammatory reaction. | 1 |
| 04:11, 21 August 2013 | IPLab10Crypto6.jpg (file) |  |
77 KB | This is a high-power photomicrograph of the cryptococcal lesion. Some of the organisms have been expelled during processing, but some cryptococcal organisms can be seen (arrows). | 1 |
| 04:11, 21 August 2013 | IPLab10Crypto5.jpg (file) |  |
71 KB | This is a higher-power photomicrograph of the cryptococcal lesion. The air spaces are filled with organisms (arrows). | 1 |
| 04:11, 21 August 2013 | IPLab10Crypto4.jpg (file) |  |
52 KB | This is a low-power photomicrograph of the lung from the lesion seen on x-ray. Note that there is little, if any, inflammatory reaction. | 1 |
| 04:10, 21 August 2013 | IPLab10Crypto3.jpg (file) |  |
67 KB | This is another section of this lung showing consolidation (arrows). | 1 |
| 04:10, 21 August 2013 | IPLab10Crypto2.jpg (file) |  |
83 KB | This is a gross photomicrograph of this lung taken at autopsy. Note the areas of emphysema (1) and consolidation (2). | 1 |
| 04:10, 21 August 2013 | IPLab10Crypto1.jpg (file) |  |
23 KB | This is the chest x-ray showing the mass (arrow) in the right lower lobe. | 1 |
| 04:07, 21 August 2013 | IPLab10Histo7.jpg (file) |  |
34 KB | This photomicrograph was taken under oil immersion to show the silver-stained Histoplasma organisms. Some of the organisms appear to be budding (arrows). | 1 |
| 04:07, 21 August 2013 | IPLab10Histo6.jpg (file) |  |
67 KB | This is a high-power photomicrograph of the same section of tissue as the previous slide. This section, however, has been stained with methenamine silver which causes the Histoplasma organisms to stain black (arrows). | 1 |
| 04:06, 21 August 2013 | IPLab10Histo5.jpg (file) |  |
66 KB | This high-power photomicrograph shows small (2-5 mm) dark-staining organisms in the cytoplasm of many of these cells (arrows). | 1 |
| 04:06, 21 August 2013 | IPLab10Histo4.jpg (file) |  |
78 KB | This high-power photomicrograph was taken at the edge of the area of necrosis. There is a mild inflammatory infiltrate along the edge of the necrosis. | 1 |
| 04:06, 21 August 2013 | IPLab10Histo3.jpg (file) |  |
90 KB | This is an even higher-power photomicrograph of an area of necrosis (arrows). There is loss of cellular detail within this area. There are inflammatory cells present; however, it is difficult to differentiate the inflammatory cells from the native lymp... | 1 |
| 04:06, 21 August 2013 | IPLab10Histo2.jpg (file) |  |
52 KB | This higher-power photomicrograph of the previous adrenal gland shows more clearly the irregularly-shaped area of necrosis (arrows). | 1 |
| 04:06, 21 August 2013 | IPLab10Histo1.jpg (file) |  |
13 KB | This low-power photomicrograph shows a section of adrenal gland with several irregularly-outlined areas of necrosis. | 1 |
| 04:04, 21 August 2013 | IPLab10Candidiasis8.jpg (file) |  |
78 KB | This is a higher-power photomicrograph of a Candida colony in the kidney. Note the pseudohyphae of the Candida organisms. | 1 |